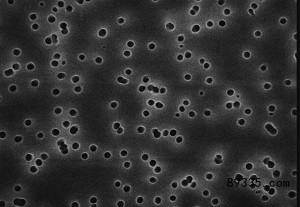

起订:1
供应:888800
发货:3天内
北京德隆伟业科技有限公司
Isopore表面虑膜是在聚碳酸酯表面径迹蚀刻而成,**用于所有需要在膜表面观察样品的分析。 Isopore表面虑膜具有*特的适用性,通过光学或电子显微镜技术对空气中的污染物及其它颗拉进行观察分析。 Isopore表面虑膜由聚碳酸酯膜组成,具有光滑的,像玻璃一样的表面,可以进行清晰的样品观察。该表面滤膜*有的生产工艺保证了**均一的孔径,可进行**的依据孔径的离。 Isopor表面虑膜不会污染,具有很低的背景干扰。 在绝大多数透射显微镜应用中无需进行清洗。因为焦油和灰份重里低且稳定,所以通常不需要重量配对滤膜。 Isopore表面虑膜是不吸湿的,可以很快干燥,缩短样品分析时间 技术指标 颜色:白色或黑色 表面:光面 可湿性:亲水 厚度:7-22um 成孔率:5-20% 灭菌方法:高温高压灭菌(121°C,1bar)、EO或Y射线灭菌 使用温度:140°C较大 胰岛素吸收率:3ug/cm 应用 代码 颜色 孔径 泡点 水的流速 空气流速 趋药性分析,细胞学,空气监测生物分析 VMTP 白色 0.05 7.1 0.35 VCTP 白色 0.1 7.1 0.5 1.5 趋药性分析,细胞学,空气监测,sem分析,无菌实验 GTTP 白色 0.2 3.5 6 1 落射荧光显微术,颗粒检测,空气监测 GTBP 黑色 0.2 3 16 3 可吸收的卤化物分析,颗粒检测,空气监测 HTTP 白色 0.4 3 18 10 落射荧光显微术,颗粒检测,空气监测 HTTP 黑色 0.4 2 30 7.5 反射光显微术,sem分析,空气监测,重量分析 DTTP 白色 0.6 1.5 25 10 反射光显微术,sem分析,空气监测,重量分析,石棉监测 ATTP 白色 0.8 1.2 40 20 趋药性分析,细胞学,空气监测生物分析 RTTP 白色 1.2 1 110 20 TTTP 白色 2 0.28 350 22 TSTTP 白色 3 0.05 1500 50 寄生虫学,细胞学,空气监测生物分析 TMTTP 白色 5 2000 50 趋药性分析,细胞学,空气监测生物分析 TETTP 白色 8 250 60 TCTTP 白色 10 250 69 TKTTP 白色 12 250 127 订购信息: 白色过滤膜 孔径 滤膜直径 数量包装 目录编号 0.05 13 100 VMTP 013 00 25 100 VMTP 025 00 47 100 VMTP 047 00 90 30 VMTP 090 00 142 50 VMTP142 00 0.1 13 100 VCTP 013 00 25 100 VCTP 025 00 47 100 VCTP 047 00 142 50 VCTP 142 00 0.22 13 100 GTTP 013 00 25 100 GTTP 025 00 37 100 GTTP 037 00 47 100 GTTP 047 00 142 50 GTTP 142 00 0.4 13 100 HTTP 013 00 25 100 HTTP 025 00 37 100 HTTP 037 00 47 100 HTTP 047 00 90 30 HTTP 090 00 142 50 HTTP 142 00 0.6 13 100 DTTP 013 00 25 100 DTTP 025 00 47 100 DTTP 047 00 142 50 DTTP 142 00 0.8 13 100 ATTP 013 00 25 100 ATTP 025 00 37 100 ATTP 037 00 47 100 ATTP 047 00 142 50 ATTP 142 00 1.22 13 100 RTTP 013 00 25 100 RTTP 025 00 47 100 RTTP 047 00 142 50 RTTP142 00 2 13 100 TTTP 013 00 25 100 TTTP 025 00 47 100 TTTP 047 00 142 50 TTTP 142 00 3 13 100 TSTP 013 00 25 100 TSTP 025 00 47 100 TSTP 047 00 142 50 TSTP 142 00 5 13 100 TMTP 013 00 25 100 TMTP 025 00 47 100 TMTP 047 00 90 30 TMTP 090 00 142 50 TMTP 142 00 8 13 100 TETP 013 00 25 100 TETP 025 00 47 100 TETP 047 00 90 30 TETP 090 00 142 50 TETP 142 00 10 13 100 TCTP 013 00 25 100 TCTP 025 00 47 100 TCTP 047 00 142 50 TCTP 142 00 12 13 100 TKTP 013 00 25 100 TKTP 025 00 47 100 TKTP 047 00 黑色过滤膜 0.22 13 100 GTBP 013 00 25 100 GTBP 025 00 47 100 GTBP 047 00 0.4 13 100 HTBP 013 00 25 100 HTBP 025 00 47 100 HTBP 047 00
状态:离线 发送信件 在线交谈
姓名:李女士(经理)电话:1532108700(先生)
电话:15321087006
手机:15321087006
地区:北京
地址:北京丰台北京市门头沟区石龙经济技术开发区永安路20号
邮件:bjdlwykj@zgny.com
QQ:346655709